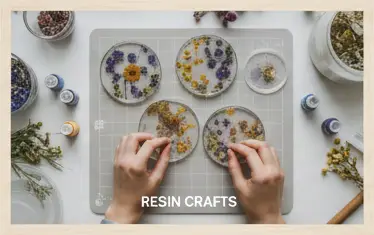

Explore Now



+91 99055 66789
No products in the cart.




From sleek business cards and neon signage to handcrafted gifts and decor.
We bring ideas to life with precision and creativity.
Custom 3D Printed Gifts & Home Decor in India
Creative printing, signage, and custom-crafted products designed to elevate your business, home, or event.







Discover a magical world of toys that spark joy, learning, and imagination.


Precision 3D Printing
Convenient Delivery
Best Price Guarantee
Services and Services
Fully Customizable Designs
Fully Secured Delivery
Latest Design
Equipment Acceptance

Transform any room with our modern 3D-printed home decor
โ lamps, vases, and quirky accents.

Customized Fast Charging Pad

Customized Mobile Cover
Transform any room with our modern 3D-printed home decor โ lamps, vases, and quirky accents.